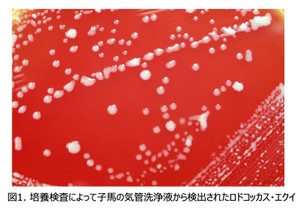

国内における多剤耐性ロドコッカス・エクイの出現
馬産地である日高管内ではあちこちで馬の親子を見かけるようになってきました。このような微笑ましい光景が見られる一方、この時期は生産者の皆様にとって頭を悩ます子馬の感染症であるロドコッカス・エクイ感染症が猛威を振るい始める時期でもあります。
ロドコッカス・エクイ感染症は、主に1〜3ヶ月齢の子馬が感染し、肺炎や腸炎などを引き起こす病気として知られています。馬の飼養環境中の土壌中には病気の原因となるロドコッカス・エクイ(図1)という菌が生息しており、空気中に巻き上げられた菌を子馬が肺の中に吸い込むことによって感染が起こります。ロドコッカス・エクイ感染症は、早く発見し、すぐに抗菌薬による適切な治療が行われれば、ほとんどが問題なく回復する病気です。しかし、米国では2000年ごろから治療の切り札となるアジスロマイシンなどのマクロライド系抗菌薬とリファンピシンの両方に対して抵抗性もった株、すなわち多剤耐性株が増加していることが明らかとなってきました(図2)。Giguèreら(2010)は、米国のある診療施設において多剤耐性株によって感染した子馬の生存率(25.0%)が、耐性を持たない株の生存率(69.6%)と比較して有意に低かったことを報告しました。このことから、多剤耐性株の存在は、ロドコッカス・エクイ感染症の治療の中で最も脅威となる要因として認識されるようになってきています。
この米国における多剤耐性株の増加は、特定のクローン(同じ遺伝的な特徴を持つ株同士の集まり)の増加が原因となっていました。このクローンは、最近まで米国内に限って検出されていましたが、2016年には大西洋を越えてアイルランドに広がり、2022年には太平洋を越えて日本国内でも検出されました。今後、馬の移動とともに世界中の馬産地に拡散してしまうことが大変危惧されています。幸いなことに、現在のところ国内ではこのクローンによる感染の広がりは限定的ですが、ワクチンなどの有効な予防方法が存在しない感染症であることから、米国で起きてしまったような多剤耐性株の増加は防がなければなりません。そのためには、①必要な場合のみ抗菌薬による治療を行う②薬剤感受性試験を行い有効な抗菌薬を使用する③多剤耐性株による感染状況を監視するといった基本的な対策が重要です。現在、日高管内では馬関係団体とJRA競走馬総合研究所が協力し、多剤耐性株の監視を続けています。
日高育成牧場 生産育成研究室 丹羽 秀和